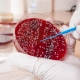

-
Егор Алёшин: я беру лучшее из спорта и перекладываю это на жизнь и бизнес400815 апреля 2026 -
Екатерина Конева и Азамат Макенов: идя в бизнес, многие хотят проработать свою травму, не зная этого559707 апреля 2026 -
Илья Муренец: деньги — это не главное, главное — удовлетворение от того, что ты сделал995311 марта 2026
-
Вацлав Дембовский, режиссер Омской драмы: Центр Омска абсолютно волшебный87329 апреля 2026 -
Дмитрий Предыбайло: я хотел бы видеть омский «Нефтяник-Титан» небезразличной командой111529 апреля 2026 -
Екатерина Конева и Азамат Макенов: идя в бизнес, многие хотят проработать свою травму, не зная этого559707 апреля 2026
-
Омский стилист рассказала, как внешний вид влияет на сделки и доверие155128 апреля 2026 -
Прогноз на серию «Авангарда» и ЦСКА дали омские предприниматели650908 апреля 2026 -
Омский стилист рассказала, как меняется деловой дресс-код732901 апреля 2026 -
Омские спортсмены дали свои прогнозы на серию «Авангарда» и «Нефтехимика»764424 марта 2026
-
Омская бизнесвумен поделилась вайбом от поездки в Ташкент47430 апреля 2026 -
Галина Толмачева создавала омскую моду вопреки столичному снобизму337524 апреля 2026 -
Звезда Омского Камерного театра обнародовала свои девичьи фото328723 апреля 2026 -
Художник Никас Сафронов не согласен быть голодным279023 апреля 2026 -
Закулисье: в Омском «Пятом театре» показали, как идут репетиции премьеры (ФОТО)302822 апреля 2026 -
Ольга Бузова продолжит актерскую карьеру325822 апреля 2026 -
Микст-зона: смешанные пары впервые искали победителя в омском клубе "RUSSКИЙ"297621 апреля 2026
Новости партнеров